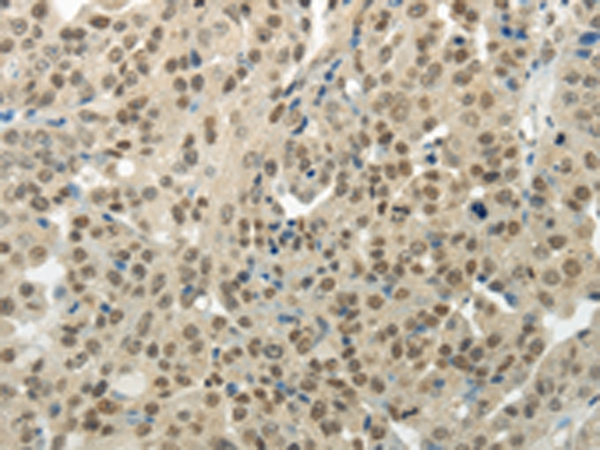

WSTF Antibody (YA2224, Rabbit)
HY-P82479
TargetBAZ1B
Product group Antibodies
Overview
- SupplierMedChem Express
- Product NameWSTF Antibody (YA2224, Rabbit)
- Delivery Days Customer5
- CertificationResearch Use Only
- ClonalityMonoclonal
- Gene ID9031
- Target nameBAZ1B
- Target descriptionbromodomain adjacent to zinc finger domain 1B
- Target synonymsWBSCR10, WBSCR9, WSTF, tyrosine-protein kinase BAZ1B, hWALp2, transcription factor WSTF, williams syndrome transcription factor, williams-Beuren syndrome chromosomal region 10 protein, williams-Beuren syndrome chromosomal region 9 protein
- HostRabbit
- IsotypeIgG
- Scientific DescriptionWSTF Antibody (YA2224) is a rabbit-derived non-conjugated IgG antibody (Clone NO.: YA2224), targeting WSTF, with a predicted molecular weight of 171 kDa (observed band size: 185 kDa). WSTF Antibody (YA2224) can be used for WB, FC experiment in human, mouse, rat background.
- UNSPSC41116161